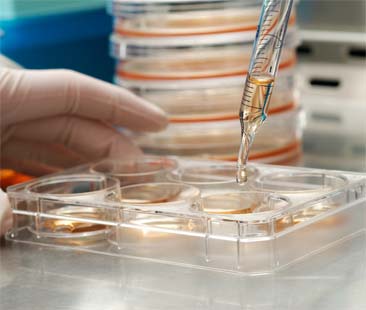
Sclerosi multipla, investimenti nella ricerca ancora insufficienti

CATANIA – Può iniziare con l’offuscamento della vista, formicolio e bruciore alle estremità, perdita di sensibilità. Ma soprattutto comincia con la stanchezza che prosciuga ogni forza vitale. Così vivere o meglio, sopravvivere, diventa un’impresa. Ed è solo l’inizio. Purtroppo è una condanna al peggioramento perché oggi non si guarisce dalla sclerosi multipla.
In Italia sono circa 65 mila i malati, 6 mila solo in Sicilia e ogni 4 ore si registra un nuovo caso. In tutto il mondo le cifre salgono a 2,5 mln di pazienti cronici. Particolare insorgenza si registra in Sardegna dove c’è un malato ogni 700 abitanti.
Le medicine per tenere sotto controllo la patologia comportano una spesa nazionale di 2,2 mld l’anno, circa 34 mila euro a paziente. In Sicilia si stima quindi una spesa di 203 mln. I farmaci sono coperti dal sistema sanitario e spesso costano molto.
In Italia sono circa 65 mila i malati, 6 mila solo in Sicilia e ogni 4 ore si registra un nuovo caso. In tutto il mondo le cifre salgono a 2,5 mln di pazienti cronici. Particolare insorgenza si registra in Sardegna dove c’è un malato ogni 700 abitanti.
Le medicine per tenere sotto controllo la patologia comportano una spesa nazionale di 2,2 mld l’anno, circa 34 mila euro a paziente. In Sicilia si stima quindi una spesa di 203 mln. I farmaci sono coperti dal sistema sanitario e spesso costano molto.
Dal punto di vista medico, si interviene sull’infiammazione, causata dall’ammaloramento del sistema nervoso centrale, attraverso l’impiego di cortisonici ai quali si aggiungono altri farmaci per il trattamento della malattia a lungo termine. La sclerosi multipla infatti è cronica, imprevedibile e invalidante. Le cause ambientali sono ancora in fase di studio mentre è stata appurata la trasmissione genetica, attivata comunque da cause esterne (come le infezioni virali) che indeboliscono il sistema immunitario permettendo alla sclerosi di esplodere dentro al corpo. L’esordio della malattia è tra i 15 e i 50 anni, ma di frequente si manifesta tra i 20 e i 30 anni. La sclerosi multipla colpisce soprattutto le donne, con un rapporto di 3 a 1 rispetto agli uomini. Ogni anno, nel nostro Paese, si fanno circa 1.800 nuove diagnosi e una persona ogni 1.000 viene colpita dalla malattia nel corso della propria vita.
Immaginate di non potervi muovere. Di non avere più il controllo delle gambe o di non riuscire a prendere e tenere in mano un bicchiere o addirittura una penna. E poi pensate che ogni giorno, oltre a svariate pillole e fiale, dovete fare una puntura, ogni giorno nella pancia o nelle cosce. I farmaci possono costare migliaia di euro e vanno tenuti in frigo. E il liquido medicinale che riempie la siringa è doloroso quando penetra nei tessuti, è oleoso e va massaggiato ma solo dopo 15 minuti di completa immobilità. Aggiungete altri 15 minuti prima dell’iniezione per passare un po’ di ghiaccio sulla parte in modo da aggirare il dolore. Sembra quasi un controsenso: una malattia neurologica che toglie la sensibilità e drena le forze ma che continua a far percepire il dolore. E comunque la patologia può sempre peggiorare.
Fino a qualche anno fa una persona con sclerosi multipla aveva il 70 per cento di possibilità di dover ricorrere alla sedia a rotelle entro 15 anni dalla diagnosi, mentre oggi questo rischio si attesta intorno al 30 per cento ed entro i 25 anni dalla diagnosi. È necessario tenere sotto controllo i valori del sangue ed evitare l’esposizione al sole che provoca rush cutanei e macchie pruriginose sulla pelle.
Spesso poi, è difficile far capire all’esterno l’estensione e la gravità dei sintomi che compromettono la vita quotidiana e quella lavorativa. I lavoratori malati non garantiti dal tempo indeterminato potrebbero incontrare forti difficoltà per inserirsi e restare nel mondo del lavoro.
L’unica cosa che tutti possono fare è aiutare la ricerca perché possa scoprire le cause, incrementare l’impiego di farmaci immunomodulanti, così definiti perché riducono l’intensità con cui il sistema immunitario aggredisce quello nervoso, e studiare la relazione tra sclerosi, infezioni virali e neoplasie in modo da gestire i malati in via preventiva. L’AISM – Associazione Italiana Sclerosi Multipla – è il primo finanziatore della ricerca sulla sclerosi multipla in Italia ed è tra i primi finanziatori mondiali dopo Stati Uniti e Canada. Sono 35 milioni di euro gli investimenti di AISM nella ricerca negli ultimi 22 anni. Ogni anno, tre milioni di euro vengono messi a disposizione dei ricercatori con il bando FISM – Federazione Internazionale Sclerosi-. Si studia inoltre come usare le cellule staminali contro la malattia.
Cure alternative. “Posso camminare grazie alla cannabis”
Ha generato scalpore la lettera di una paziente leccese che si descrive così: “Mi chiamo Lucia, ho 30 anni e la sclerosi multipla. Stavo su una sedia a rotelle, ora grazie alla cannabis cammino”. La testimonianza di una ragazza curata nel centro di Casarano – dove dal 2011 la regione Puglia sperimenta gratis il trattamento a base di marijuana- suscita forte interesse. La giovane si definisce “una dei cinque fortunati pazienti” cha hanno avviato il trattamento e descrive i “miglioramenti evidenti ed eclatanti nell’andatura, nei tremori, nei dolori, negli spasmi muscolari, nella rigidità, nell’appetito, nell’umore e nel miglioramento totale della qualità di vita”. La delibera della giunta regionale pugliese firmata a febbraio dall’allora assessore alla Salute Tommaso Fiore autorizza l’erogazione dei cannabinoidi a scopo terapeutico a carico del servizio sanitario regionale, uno degli ultimi atti del primo governo Vendola. In realtà il provvedimento si limita a recepire un decreto ministeriale del 2007, ma costituisce uno dei testi più avanzati in tutta Italia sull’utilizzo clinico della cannabis. Come la Puglia solo la Toscana. Ogni Asl dovrà garantire La copertura dei costi.